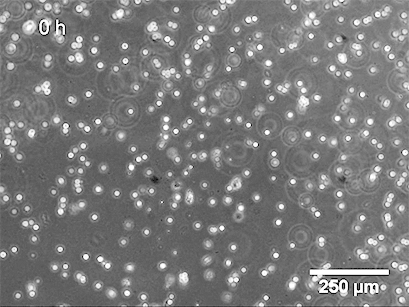
82.png

date:2021-09-09 11:26:35
#應用指南#

血管網絡由哺乳動物生物體中的各種功能組成。血管將流體、氣體、分子和細胞輸送到身體的每個部位。此外,免疫細胞利用血管在全身巡邏,保護我們免受細菌、病毒和寄生蟲的侵害。
血管形成是發育、健康和疾病過程中的關鍵過程。例如,在成人中,它發生在傷口愈合、骨骼生長、懷孕期間。血管生長失調通常與嚴重疾病有關,例如中風、心肌梗塞、動脈硬化和關節炎。此外,腫瘤血管化是癌癥的標志之一。

# 血管新生和血管生成 #
管網絡由兩種不同的機制形成:血管新生和血管生成。
血管新生是血管的從頭形成。中胚層前體細胞(成血管細胞)分化成內皮細胞,然后組裝起來形成新的動脈和靜脈。
血管生成是通過從現有血管發芽來擴展血管網絡。
這一系列細胞事件包括細胞通過基底膜破裂、細胞遷移、細胞增殖和細胞間通訊。
這種嚴格調控的過程的驅動刺激之一是缺氧,它會誘導幾種促血管生成基因的表達。因此,血管生成的抑制或激活提供了許多治療機會。
例如,使用貝伐單抗阻斷促血管生成血管內皮生長因子 (VEGF) 已被證明可以改善許多轉移性結直腸癌 (mCRC) 和非小細胞肺癌 (NSCLC) 患者,盡管仍然存在一些耐藥性。血管生成分析可以深入了解各種藥物的促血管生成或抗血管生成潛力,從而有助于開發新的治療方法。


在血管生成期間,新血管從現有血管延伸。例如,內皮細胞突破基底膜并朝著由癌細胞、活化的巨噬細胞或淋巴細胞產生的血管生成刺激的方向遷移。在這個遷移前沿的背后,細胞增殖和重組以形成新的三維血管。
# 血管形成和分析 #
在我們的身體中,內皮細胞被基底膜包圍,基底膜是一種薄且高度特化的細胞外基質 (ECM)。當內皮細胞,例如人臍靜脈細胞 (HUVEC) 被接種到基底膜樣表面(例如 Matrigel ®)上時,它們會在體外形成毛細血管樣結構,從而重現血管生成。

這種所謂的管形成試驗已被廣泛應用于解決各種實驗問題,例如:
1.特定藥物的促血管生成或抗血管生成潛力是什么?
2.哪些基因和通路參與血管生成?
3.抑制劑或增強劑對管形成有何影響?
4.血管生成過程中信號如何轉導?
5.血管生成過程中的細胞骨架效應是什么?
6.哪些細胞是內皮祖細胞?

使用 ibidi Stage Top Incubation System 的活細胞成像 顯示了管形成試驗中 HUVEC 的管形成。
基底膜表面及其成分是管形成試驗成功的關鍵。可以應用不同類型的基底膜(例如,Matrigel ®、膠原蛋白或其他水凝膠基質),這會導致不同的管形成率。內皮細胞在形態上分化形成管。細胞首先附著在基質上并相互遷移。然后,它們附著在其他細胞上,對齊并形成毛細管狀管。管子成熟直到細胞最終經歷細胞凋亡,導致從表面脫離和管子破壞。
管形成試驗是通過首先接種單個細胞,然后隨著時間的推移觀察和成像管形成來進行的。隨著時間的推移,可以對幾個讀數進行成像和分析,例如管長度和循環數。通常,管子在幾個小時內形成,使管子形成分析成為胚胎發育、癌癥、傷口愈合和組織修復研究領域中血管生成定量的快速工具。

在µ-Slide 血管生成中的管形成測定期間,由 HUVEC 細胞組成的單鏈的相差(上圖)和熒光觀察(下圖)。F-肌動蛋白細胞骨架被染成綠色,細胞核被染成藍色。
# 發芽試驗 #

類似于管形成試驗,發芽試驗也可用于量化體外血管生成。
在這里,多細胞球體或組織塊(例如,來自主動脈)被置于凝膠基質(例如,Matrigel ®、膠原蛋白)中或之上,然后它們在那里形成芽。
為了進行分析,在定義的時間點對細胞簇的發芽進行成像,并測量發芽長度。發芽試驗與管形成試驗一樣,需要明確定義的凝膠層厚度,這在使用µ-Slide Angiogenesis和 µ-Plate Angiogenesis 96 Well時是標準化的 。
# 血管新生和血管生成 #

開始實驗之前需要回答以下問題:
1、哪種細胞密度最適合我的實驗?
確定正確的細胞數量對于從管形成試驗中獲得最佳結果至關重要。細胞密度取決于細胞類型和細胞大小。在開始實際實驗之前,我們建議在非抑制條件下接種幾個細胞數并對管形成進行成像。創建的管數最多的細胞密度將顯示出最明顯的物質效應,因此應用于實驗。請記住,細胞通常不會在凝膠基質上增殖。通常,我們建議每孔使用 5,000–10,000 個 HUVEC。
2、我應該使用哪種凝膠基質?
內皮細胞的管形成率取決于形成基底膜樣細胞外基質 (ECM) 表面的凝膠的類型和成分,細胞在該表面上接種。幾種基底膜提取物可獲得,例如 Matrigel® 和 Cultrex®.,兩者均由 Engelbreth-Holm-Swarm (EHS) 鼠肉瘤細胞分泌。在開始使用特定內皮細胞類型進行實驗之前,我們建議測試幾種基底膜物質并遵循已發布的說明。如果將在您的分析中測試促血管生成劑,則應使用減少生長因子的凝膠基質。此外,如果可能,在整個實驗中使用相同的批次。
3、實驗中應包括哪些對照?
為了對您的結果進行正確的統計分析,包括陽性和陰性對照非常重要。作為陽性對照,在不使用任何抑制劑的情況下對您感興趣的細胞系進行管形成試驗。當在含有饑餓培養基的生長因子減少的 Matrigel® 上培養時,內皮細胞應在幾小時內顯示出管的形成。作為陰性對照,可以使用不影響細胞活力的管形成抑制劑。
4、我的移液器工作準確嗎?它們是否經常校準?
為避免在使用 µ-Slide 血管生成時凝膠基質形成彎液面,將準確數量的 10 µl 移入內孔至關重要。此外,接種正確的細胞數非常重要。因此,有必要使用處于完美工作狀態的校準移液器。我們建議用相應的凝膠潤濕移液器吸頭,然后使用這個吸頭填充孔。
5、我應該在哪個時間段內觀察細胞?
管形成的持續時間取決于細胞類型和所使用的細胞外基質,應單獨確定。通常,HUVEC 在 2-4 小時后已經形成管。24 小時后,細胞開始發生凋亡,這會導致從基質上脫離和管子破裂。

6、我應該手動還是自動監測管子的形成?
如果有活細胞成像設備,我們建議使用延時視頻成像——尤其是當您不熟悉所用細胞類型的血管生成行為時。在典型的設置中,在 24 小時的時間范圍內每 5-15 分鐘自動拍攝一張照片。這使得能夠精確監控管形成的進程,例如,在添加特殊物質之后。如果您已經知道管形成的大致時間范圍,也可以在預期的感興趣時間點手動拍照。
#ibidi血管生成載玻片原理 #
1、樣品制備
使用 µ-Slide 血管生成時,由于采用孔中嵌孔技術,凝膠基質的量減少到每孔 10 µl。
將凝膠基質(例如 Matrigel ®、膠原凝膠或水凝膠)移入 µ-Slide 血管生成的下部孔中。培養直到凝膠聚合,然后將細胞接種到上孔中。接種后不久,細胞會下沉到凝膠表面,然后就可以進行觀察了。

2、活細胞成像
3、數據分析

圖像采集后,可分析管面積、管長、管數、環面積、環數、芽數等參數。這可以手動執行,也可以使用自動化軟件執行。參數的統計比較(單獨或組合)將概述不同條件下管形成的程度。
ICP備案號:
滬ICP備15057650號-1
 滬公網安備31011202005471
滬公網安備31011202005471
雷萌生物科技(上海)有限公司 保留所有版權.